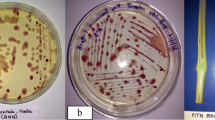

Abstract
Bacterial wilt triggered by Ralstonia solanacearum is one of the major devastating diseases causing significant yield reduction in eggplant. F1 hybrids (18 CARI-1 based F1 hybrids and 12 publicly available hybrids/varieties) were evaluated for bacterial wilt resistance, yield, and yield attributing traits. CARI-1 based F1 hybrids showed superiority in yields, however showed a varied level of resistance to bacterial wilt. Further, inheritance and gene action involved in resistance to Ralstonia solanacearum was studied. CARI-1 was crossed with two susceptible parents, Arka Neelachal Shyama and Pusa Purple Long to develop six generations for both the combinations. The genetic control of resistance to bacterial wilt was found to be polygenic in the case of the Arka Neelachal Shyama x CARI-1 derived population. While di-genic with complementary gene action in the case of Pusa Purple Long x CARI-1 F2 population, however deviation in expected ratios was observed in back cross populations. Generation mean analysis revealed the presence of epistasis. For Arka Neelachal Shyama x CARI-1 derived population, owing to the prevalence of additive × additive non-allelic interaction with a negative sign, delaying of selection to later generations, otherwise inter mating between the selected segregates accompanied by selfing for one or more generation(s) is advised for the aggregation of favorable alleles for enhancement of resistance. Similarly, for Pusa Purple Long x CARI-1 population, the simple selection can be efficient due to the prevalence of additive gene action. The inheritance details accumulated in this study would facilitate the introgression of bacterial wilt resistance into elite commercial genotypes.


Similar content being viewed by others
References
Acharya, B., Ghorai, A. K., Dutta, S., Maurya, P. K., Dutta, S., Mandal, A. K., & Hazra, P. (2018). Genetics of tolerance to bacterial wilt disease in tomato (Solanum lycopersicum L.). Australasian Plant Pathology, 47(6), 591–600.
Ajjappalavara, P. S., Dharmatti, P. R., Salimath, P. M., Patil, R. V., Patil, M. S., & Krishnaraj, P. U. (2008). Genetics of bacterial wilt resistance in brinjal. Karnataka. Journal of Agricultual Scence, 21, 424–427.
Akira, M. N., Masao, K. S., Hideki, T., & Shigehito, T. (2009). Visualization of Ralstonia solanacearum cells during biocontrol of bacterial wilt disease in tomato with Pythium oligandrum. Journal of General Plant Pathology, 75, 281–287.
Bainsla, N. K., Singh, S., Singh, P. K., Kumar, K., Singh, A. K., & Gautam, R. K. (2016). Genetic behavior of bacterial wilt resistance in brinjal (Solanum melongena L.) in tropics of Andaman and Nicobar islands of India. American Journal of Plant Science, 7, 333–338.
Bhutia, N. D., Seth, T., Shende, V. D., Dutta, S., & Chattopadhyay, A. (2015). Estimation of heterosis, dominance effect and genetic control of fresh fruit yield, quality and leaf curl disease severity traits of chilli pepper (Capsicum annuum L.). Scientia Horticulturae, 182, 47–55.
Buyela, D. K., David, M. M., George, T. O., & Pascaline, J. (2017). Isolation and characterization of Ralstonia solanacearum strains of tomato wilt disease from Maseno, Kenya. Journal of Asian Scientific Research, 7(9), 404–420.
Campbell, C. L., & Madden, L. V. (1990). Introduction to plant disease epiodemiology. New York: John Wiley and sons.
Cao, B. H., Lei, J. J., Wang, Y., & Chen, G. J. (2009). Inheritance and identification of SCAR linked to bacterial wilt-resistance in eggplant. African Journal of Biotechnology, 8, 5201–5207.
Cavalli, L. L. (1952). A joint-scale test. In E. C. R. Rieve & C. H. Waddington (Eds.), An analysis of linkage in quantitative inheritance (pp. 135–144). London: HMSO.
Chandrashekara, K. N., Prasannakumar, M. K., Deepa, M., Vani, A., & Khan, A. N. A. (2012). Prevalence of races and biotypes of Ralstonia solanacearum in India. Journal of Plant Protection Research, 52(1), 53–58.
Chattopadhyay, A., Seth, T., Dutta, S., Ghosh, P. P., Chattopadhyay, S. B., Majumder, D., & Hazra, P. (2012). Breeding eggplant for higher productivity and bacterial wilt tolerance. International journal of vegetable science, 18(4), 376–392.
Chaudhary, D. R. (2000). Inheritance of resistance to bacterial wilt (Ralstonia solanacearum E. F. Smith) in eggplant. Haryana Journal of Horticultural Sciences, 29, 89–90.
Choudhary, D. K., Sun, N., Dar, M. S., & Khan, K. A. (2018). Ralstonia solanacearum: A wide spread and global bacterial plant wilt pathogen. Journal of Pharmacognosy and Phytochemistry, 7(2), 85–90.
Daunay, M. C., & Hazra, P. (2012). In: Peter, K.V., Hazra, P. (Eds.), “Eggplant,” in Handbook of Vegetables (pp. 257–322). Houston:Studium Press.
de Mendiburu, F. (2014). Agricolae: Statistical procedures for agricultural research. http://CRAN.R-project.org/package=agricolae, R package version 1.2–1.
Denny, T. P. (2006). In S. S. Gnanamanickam (Ed.), Plant pathogenic Ralstonia species. In Plant-Associated Bacteria (pp. 573–644). Dordrecht, The Netherlands: Springer.
Du, H., Chen, B., Zhang, X., Zhang, F., Miller, S. A., Rajashekara, G., & Geng, S. (2017). Evaluation of Ralstonia solanacearum infection dynamics in resistant and susceptible pepper lines using bioluminescence imaging. Plant Disease, 101(2), 272–278.
FAOSTAT (2018). http://www.fao.org/faostat/en/
Fegan, M., & Prior, P. (2005). How complex is the ‘Ralstonia solanacearum species complex?’. In C. Allen, P. Prior, & A. C. Hayward (Eds.), Bacterial wilt disease and the Ralstonia solanacearum species complex (pp. 449–461). MN: APS press, Saint Paul.
Gopalakrishnan, C., Singh, T. H., & Artal, R. B. (2014). Evaluation of eggplant accessions for resistance to bacterial wilt caused by Ralstonia solanacearum (E.F. smith). Journal of Horticultural Science, 9, 202–205.
Hayman, B. I. (1958). Separation of epistatic from additive and dominance variation in generation means. Heredity, 12, 371–390.
Hayman, B. I., & Mather, K. (1955). The description of genetic interaction in continuous variation. Biometrics, 11, 69–82.
Huet, G. (2014). Breeding for resistances to Ralstonia solanacearum. Frontiers in Plant Science, 5, 715.
Ishihara, T., Mitsuhara, I., Takahashi, H., & Nakaho, K. (2012). Transcriptome analysis of quantitative resistance-specific response upon Ralstonia solanacearum infection in tomato. PLoS One, 7, e46763.
Jinks, J. L., & Jones, R. M. (1958). Estimation of components of heterosis. Genetics, 43, 223–234.
Khapte, P., Singh, T. H., & Lakshmana, D. C. (2018). Screening of elite eggplant (Solanum melongena) genotypes for bacterial wilt (Ralstonia solanacearum) in field conditions and their genetic association by using SSR markers. Indian Journal of Agricultural Science, 88(10), 1502–1511.
Krishna, K., Singh, P. K., Ajanta, B., Shrawan, S., Naresh, K., Singh, A. K., Singh, D. R., & Gautam, R. K. (2012). CARI eggplant-1 (IC0585684; INGR12015), an eggplant germplasm with bacterial wilt resistance. Indian Journal of Plant Genetic Resources, 25, 323–324.
Kumar, R., Esakky, R., & Yadav, K. (2019). Phylotype analysis of Ralstonia Solanacearum causing bacterial wilt in eggplants in Orissa in India. International Journal of Trend in Scientific Research and Development, 3(3), 1–3.
Kurhade, G. M., Bhave, S. G., Sawardekar, S. V., Burondkar, M. M., & Dalvi, V. V. (2017). Genetic behavior of bacterial wilt resistance in f2 population of brinjal (Solanum melongena L.). Journal of Research ANGRAU, 45(2), 1–5.
Lebeau, A., Gouy, M., Daunay, M. C., Wicker, E., Chiroleu, F., Prior, P., Frary, A., & Dintinger, J. (2013). Genetic mapping of a major dominant gene for resistance to Ralstonia solanacearum in eggplant. Theoretical and Applied Genetics, 126, 143–158.
Mak, G. (2013). Health benefits of Aubergine. Retrieved from. www.healthbenefitstimes.com. Accessed 22 Oct 2015
Mansfield, J., Genin, S., Magori, S., Citovsky, V., Sriariyanum, M., Ronald, P., Dow, M., Verdier, V., Beer, S. V., & Machado, M. A. (2012). Top 10 plant pathogenic bacteria in molecular plant pathology. Molecular Plant Pathology, 13, 614–629.
Mather, K. (1949). Biometrical genetics. New York: Dover Publications Inc..
Mather, K., & Jinks, J. L. (1982). Biometrical genetics, 3rd edn. Chapman and Hall Ltd., London.
Mensah, C., DiFonzo, C., Nelson, R. L., & Wang, D. (2005). Resistance to soybean aphid in early maturing soybean germplasm. Crop Science, 45(6), 2228–2233.
Murray, M. T. (2004). The healing power of herbs, 2nd edn. New York: Random House
Namisy, A., Chen, J., Prohen, J., Metwally, E., Elmahrouk, M., & Rakha, M. (2019). Screening of cultivated eggplant and wild relatives for resistance to bacterial wilt (Ralstonia solanacearum). Agriculture, 9(7), 157.
Nishat, S., Hamim, I., & Ibrahim, K. M. (2015). Genetic diversity of the bacterial wilt pathogen Ralstonia solanacearum using a RAPD marker. Comptes Rendus Biologies, 338, 757–767.
Pandiyaraj, P., Singh, T. H., Reddy, K. M., Sadashiva, A. T., Gopalakrishnan, C., Reddy, A. C., Pattanaik, A., & Reddy, A. D. C. L. (2019). Molecular markers linked to bacterial wilt (Ralstonia solanacearum) resistance gene loci in eggplant (Solanum melongena L.). Crop Protection, p. 124.
Panse, V. G. & Sukhatme, R. V. (1985) Statistical methods for agricultural workers (4th edn, pp. 58–62). New Delhi: P. & I. Division, ICAR.
Parihar, A. K., Dixit, G. P., & Singh, D. (2016). Gene interactions and genetics for yield and its attributes in grass pea (Lathyrus sativus L.). Journal of Genetics, 95(4), 947–956.
Prakash, N. R., Zunjare, R. U., Muthusamy, V., Chand, G., Kamboj, M. C., Bhat, J. S., & Hossain, F. (2019). Genetic analysis of prolificacy in “Sikkim primitive”—A prolific maize (Zea mays) landrace of north-eastern Himalaya. Plant Breeding, 1, 1–9.
R Development Core Team (2012). R: a language and environment for statistical computing. R foundation for statistical computing. Vienna, Austria. http://www.R-project.org/
Rai, A. K., Sadashiva, A. T., Basavaraj, Y. B., Venugopalan, R., Rao, E. S., & Nandeesha, P. (2020). Genetic analysis of bud necrosis disease caused by groundnut bud necrosis virus (GBNV) in tomato (Solanum lycopersicum L.). Euphytica, 216(8), 1–10.
Ramesh, R. (2008). Bacterial wilt in brinjal and its management. Technical bulletin no: 10, ICAR research complex for Goa (Indian Council of Agricultural Research), Ela, Old Goa- 403 402, Goa, India. http://krishi.icar.gov.in/jspui/bitstream/123456789/24432/1/TB%20No.10.pdf
Roy, A., Acharya, S., Das, S., Ghosh, R., Paul, S., Srivastava, R. K., & Ghosh, S. K. (2009). Distribution, epidemiology and molecular variability of the begomovirus complexes associated with yellow vein mosaic disease of mesta in India. Virus Research, 141, 237–246.
Saddler, G. S. (2005). Management of bacterial wilt disease. In C. Allen, P. Prior, & A. C. Hayward (Eds.), Bacterial wilt disease and the Ralstonia solanacearum species complex (pp. 121–132). St. Paul: American Phytopathological Society, APS Press.
Sarkar, S., & Chaudhuri, S. (2016). Bacterial wilt and its management. Current Science, 25, 1439–1445.
Satyaprakash, B., Reddy, A. C., Naresh, P., Meenu, K., DC, L. R., Petikam, S., & Gs, S. (2020). Breeding for bacterial wilt resistance in eggplant (Solanum melongena L.): Progress and prospects. Crop Protection, 105270.
Sekara, A., Cebula, S., & Kunicki, E. (2007). Cultivated eggplants – Origin, breeding objectives and genetic resources, A review. Folia Horticulture, 19(1), 97–114.
Sheoran, O. P., Tonk, D. S., Kaushik, L. S., Hasija, R. C., & Pannu, R. S. (1998). Statistical software package for agricultural research workers. In D. S. Hooda & R. C. Hasija (Eds.), Recent advances in information theory (pp. 139–143). CCS-HAU, Hisar: Statistics & Computer Applications. Department of Mathematics and Statistics.
Singh, A. K., Pan, R. S., & Bhavana, P. (2014). Genetic studies for quantitative traits and resistance to bacterial wilt in brinjal (Solanum melongena). International Journal of Innovative Horticulture, 3(2), 154–157.
Singh, N., Phukan, T., Sharma, P., Kabyashree, K., Barman, A., Kumar, R., Sonti, R. V., Genin, S., & Ray, S. K. (2018). An innovative root inoculation method to study Ralstonia solanacearum pathogenicity in tomato seedlings. Phytopathology, 108(4), 436–442.
Tahat, M. M., & Sijam, K. (2010). Ralstonia solanacearum: The bacterial wilt causal agent. Asian Journal of Plant Science, 9(7), 385–393.
Thakur, A. K., Kohli, U. K., & Kumar, M. (2004). Inheritance of resistance to bacterial wilt in tomato. Indian Journal of Genetics, 64, 79–80.
Uttamrao, C, P. (2012). Tagging of bacterial wilt resistance gene in Solanum melongena var. insanum by molecular markers. M.Sc. Thesis. http://krishikosh.egranth.ac.in/ha ndle/1/5810033405.
VanElsas, J. D., Kastelein, P., VanBekkum, P., VandesWolf, J. M., DeVries, P. M., & VanOverbeck, L. S. (2000). Survival of Ralstonia solanacearum biovar 2, the causative agent of potato brown rot, in field and microcosm soils in temperate climates. Phytopathology, 90, 1358–1366.
Vasse, J., Frey, P., & Trigalet, A. (1995). Microscopic studies of intercellular infection and protoxylem invasion of tomato roots by Pseudomonas solanacearum. Molecular Plant-Microbe Interactions Journal, 8, 241–251.
Wicker, E., Grassart, L., Coranson-Beaudu, R., Mian, D., Guilbaud, C., & Fegan, M. (2007). Ralstonia solanacearum strains from Martinique (French West Indies) exhibiting a new pathogenic potential. Applied and Environmental Microbiology, 71, 6790–6801.
Xi’ou, X., Bihao, C., Guannan, L., Jianjun, L., Qinghua, C., Jin, J., & Yujing, C. (2015). Functional characterization of a putative bacterial wilt resistance gene (RE-bw) in eggplant. Plant Molecular Biology Report, 33(4), 1058–1073.
Yuliar, Y., Nion, A., & Toyota, K. (2015). Recent trends in control methods for bacterial wilt diseases caused by Ralstonia solanacearum. Microbes and Environment, 30(1), 1–11.
Author information
Authors and Affiliations
Corresponding author
Ethics declarations
Conflict of interest
The authors declare that they have no conflict of interest. The study presented in the manuscript does not involve human or animal subjects. All authors have reviewed the final version of the manuscript and agree to its submission to your journal.
Rights and permissions
About this article
Cite this article
Barik, S., Ponnam, N., G.C, A. et al. Genetic analysis of bacterial wilt resistance in eggplant (Solanum melongena L.). Eur J Plant Pathol 160, 349–364 (2021). https://doi.org/10.1007/s10658-021-02248-1
Accepted:
Published:
Issue Date:
DOI: https://doi.org/10.1007/s10658-021-02248-1